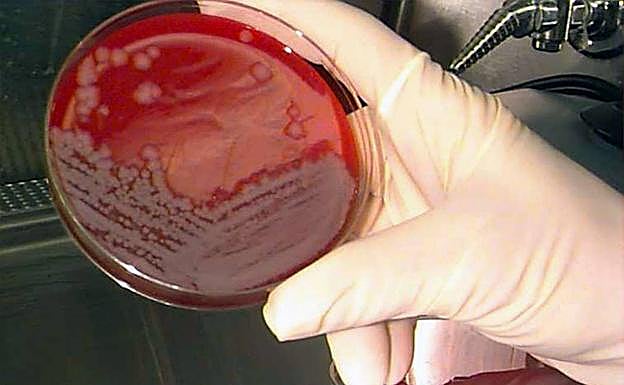

Un veterinario, contagiado de ántrax en Alburquerque
El profesional se ha contagiado supuestamente al realizar la necropsia de una vaca en una explotación ganadera de Alburquerque, en la que 87 animales serán vacunados hoy
JOSÉ TOMÁS PALACÍN
Badajoz
Jueves, 15 de septiembre 2022, 11:39
Un profesional veterinario se ha contagiado de ántrax (también conocido como carbunco) en una explotación ganadera de vacas en Alburquerque, próxima al término de la ... Codosera, ha comunicado Salud Pública de Extremadura. Al menos, lo ha identificado como el «posible origen», pues se cree que dicha persona se contagió al realizar una necropsia de una vaca.
Y es que el pasado lunes se declaró un foco de esta enfermedad por la misma zona, por lo que ha afectado al vacuno de la explotación, así que tanto el SES como Sanidad Animal están tomando cartas en el asunto. Como se trata de una enfermedad infecciosa de declaración obligatoria en España -causada por la bacteria esporulada bacillus anthraci-, los 87 animales de la ganadería se vacunarán durante el día de hoy. Cabe recordar que el ántrax afecta a gran cantidad de especies, aunque presenta una virulencia y unos síntomas clínicos variables, siendo especialmente relevante por su gravedad e incidencia en herbívoros.
El ántrax tiene tres variantes: la cutánea, que es la más leve, cuando las esporas de la enfermedad entran en la piel del manipulador de productos de origen animal -como puede ser la peletería-; la gástrica, que ya es un poco más grave, al ingerir carne cruda o casi cruda de un animal afectado, y, por último, la respiratoria, la más peligrosa de las variantes y la más letal. Subrayar también que no es contagioso entre humanos, como puede podría ser un resfriado.
Por otro lado, desde la Junta Extremadura informan que los servicios de Sanidad Animal no han podido confirmar el posible caso en la ganadería al no haber recibido el Laboratorio Nacional de Referencia para dicha enfermedad el necesario material sospechoso para efectuar los análisis y cultivos preceptivos. «No obstante, simplemente por la sospecha, se aplicarán en dicha explotación las medidas de vigilancia y control establecidas para ese supuesto», reiteran.
Noticia Relacionada
¿Qué es el ántrax o el carbunco?
Múltiples casos el año pasado
El año pasado por estas fechas, y según los datos del Sistema de Alerta Sanitaria Veterinaria del Ministerio de Agricultura en el Ministerio de Agricultura, Pesca y Alimentación (MAPA), Extremadura registró 17 focos confirmados de esta bacteria en ganaderías que estaban distribuidas por seis municipios, cinco de ellos en la provincia de Badajoz y uno en la provincia cacereña.
La cifra de caballos y vacas afectados en la comunidad extremeña por esta bacteria se disparó desde que a principios de septiembre, concretamente el día 6, se confirmase el primer caso en una yegua en la localidad pacense de Navalvillar de Pela. En este municipio se registraron un total de ocho casos en lo que se llevaba de mes. Y el último foco detectado en este municipio fue en día 24.
Ese mismo día la Junta de Extremadura también notificó al Ministerio dos casos en Casas de Don Pedro (que se sumaban a otro identificado días antes), otro en Mérida y uno más en Logrosán, población en la que ya se habían identificado otros dos casos con anterioridad.
Tras la aparición de los primeros casos el servicio de Sanidad Animal de la Junta puso en marcha un plan de vigilancia epidemiológica como medida preventiva con el fin de hacer un seguimiento de varios animales sospechosos de haber contraído la enfermedad. Se prevé que, en esta ocasión, se haga lo mismo.
¿Tienes una suscripción? Inicia sesión